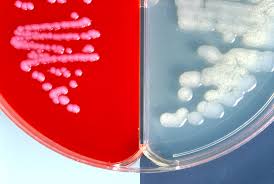

Todos los componentes químicos, en medicamentos, en su forma aislada, en las distintas presentaciones o formas, pueden llegar a ser beneficiosos para el cuerpo humano. Pero; sin las medidas preventivas correctas o la supervisión médica; puede correspondiente puede llegar a ser contradictorio o perjudicial para el organismo.
Todos los medicamentos tiene impreso las precauciones; y para la venta al público deben ser probados y estudiados para poder predecir los efectos secundarios que pueden aparecer o presentar los usuarios. Dentro de los efectos desfavorables del consumo de componentes de ácido carbónico están: edema por sobredosis de sodio, insuficiencia cardíaca y alcalosis.
Efectos Secundarios del Consumo de Bicarbonato
Problemas gástricos: sabemos que el consumo de bicarbonato es positivo para disminuir la acidez; en exceso, tiende a causar la aparición de varias complicaciones gastrointestinales (calambres, cólicos, vómitos, náusea, diarrea, etc).
Múltiples casos médicos han demostrado que el consumo exagerado de bicarbonato deteriora gravemente el sistema digestivo y ocasiona graves complicaciones.
Úlceras: Muchos estudios médicos a nivel mundial han corroborado y constatado que el resultado de la reacción que ocurre entre el bicarbonato y el ácido gástrico resulta en carbonato de sodio; y este componente es lamentablemente dañino para la mucosa que protege el estómago y por lo tanto causa úlceras terribles.
Hipertermia: el consumo inadecuado de ácido carbónico aumenta el sodio en el torrente sanguíneo, y esto ocasiona retención de líquido. La hipertermia; se trata de una condición que deteriora el equilibrio de electrolíticos en la sangre como consecuencia de un elevado nivel de sodio.
Hablamos de deshidratante, por lo tanto los síntomas serán debilidad, letargo y debilidad.
Alcalosis: un alto nivel de bicarbonato de sodio en la sangre, representa alcalinidad (aumento de pH), esta condición desfavorable para el organismo generalmente ocasiona dolorosos e insoportables calambres en los músculos, contracciones musculares, decaimiento, convulsión, taquicardia y espasmos.
Desequilibrio metabólico: Por la tendencia de elevación de pH como consecuencia del prolongado consumo de bicarbonato de sodio; surge el desequilibrio metabólico, es una condición desfavorable en el almacenamiento y liberación de la energía y la potencia; además de evitar la eficacia en la curación de lesiones y heridas.
Otros síntomas: aparte de la debilidad muscular, la confusión y el mareo, existen otros síntomas asociados al alto consumo de bicarbonato, como hinchazón de articulaciones (codos, tobillos y nudillos), heces negras, arritmia, taquicardia, edema, síndrome hiperosmolar, hipervolemia, deficiente flujo sanguíneo, hiperventilación. Para concluir podemos advertir a quienes consumen bicarbonato para algunas afecciones; tomar descansos en el consumo, consultar a su médico, y no exceder las dosis recomendadas.